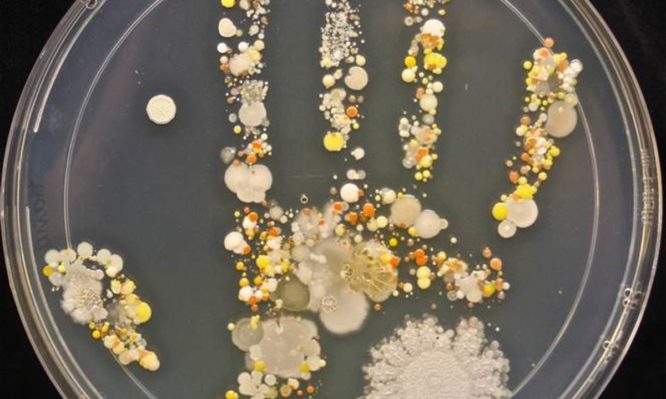

ΣΟΚ: Δείτε πόσα βακτήρια υπάρχουν στο χεράκι “κάθε” 8χρονου παιδιού
Αυτή η φωτογραφία που βλέπετε, προκάλεσε αίσθηση και ποικίλες αντιδράσεις σε όλο τον κόσμο, όταν πριν από μερικές ημέρες...
Αυτή η φωτογραφία που βλέπετε, προκάλεσε αίσθηση και ποικίλες αντιδράσεις σε όλο τον κόσμο, όταν πριν από μερικές ημέρες...